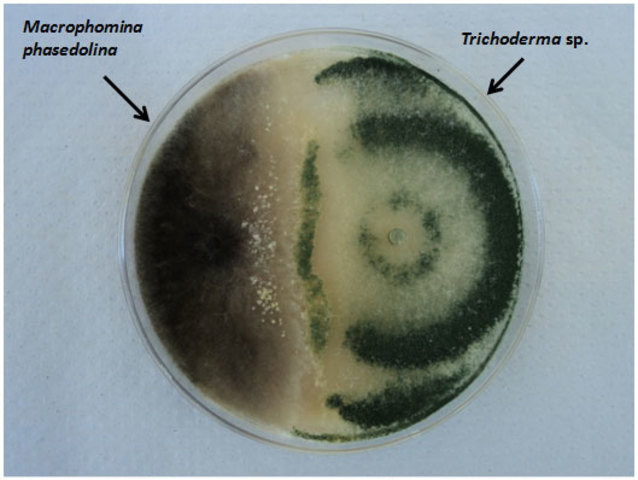
Antagonismo.

-
En el Renacimiento europeo, Girolamo Frascatorius, en su libro “De contagione et contagionis” dice que las enfermedades contagiosas se deben a “gérmenes vivos” que pasan de diversas maneras de un individuo a otro.
-
Galileo Galilei desarrolla un microscopio compuesto de una lente convexa y una cóncava.El microscopio fue utilizadao por primera vez por los componentes de la "Accademia dei Lincei" una sociedad científica a la que pertenecía Galileo y que publicaron un trabajo sobre la observación microscópica del aspecto de una abeja.
-
Descubrio la celula observando en el microscopio una lamina de corcho, dandose cuenta que estaba formada por pequeñas cavidades poliedricas que parecian celdillas de un panal, por ello cada caridad se llamo celula.
-
Desmontó la hipotesis de la generación espontanea.
Mostró la ausencia de gusanos en un frasco cerrado donde se había dejado carne pudriendose, asestando un duro golpe a la teoría de la generación espontanea. -
Anton van Leeuwenhoek fue el primero en observar bacterias y los llamo animalculos.
-
Se menciona por primera vez los espermatozoides en una carta enviada a la Royal Society, en la que habla de animálculos muy numerosos en el esperma. Leeuwenhoek fue consciente de que sus observaciones que en los testículos de los mamiferos estaba el pricipio de reproduccion.
-
Sentó las bases de la taxonomía moderna. Creo un sistema de nomenclatura binomial para clasificar a los seres vivos. Fue quien agrupó los generos en familias, estas en clases y las clases en reinos.
-
Primeros científicos observaron en primer lugar el virus de la viruela y de esta manera dieron lugar a la primera vacuna para la viruela la cual era un problema en España en esta epoca.
-
Agostino Bassi demostró que cierta enfermedad del gusano de seda, que había hecho su aparición en Lombardía, se debía a un hongo.
-
Lázaro Spallanzani comprobó que el tratamiento térmico repetido permitía evitar el crecimiento de microorganismos en infusiones. Supone un primer desarrollo de métodos de esterilización de líquidos.
-
La publicación de "Sobre el origen de las especies" por Darwin, fue utilizada por algunos preformacionistas para apoyar sus argumentos. El mismo Haeckel, en una fecha tan tardía como 1866, se mostraba escéptico ante las pruebas aportadas por Pasteur.
-
El aleman Obermeier encuentra por primera vez una bacteria, Borrelia, en la sangre de un enfermo de fiebres recurrentes, mas tarde lo comprobaria inoculando la bacteria en diez voluntarios demostrando que era patogena y causaba fiebre rrecurente.
-
John Tyndall aplicó su sistema de esterilización por calentamiento discontinuo, empezó con simples pruebas de esterilización, al descubrir que las bacterias se podían destruir por ebullición durante 5 minutos, desde allí los métodos de esterilización se empiezan a utilizar.
-
Petri. Inventor de la famosa placa Petri. Este descubrimieto de Petri, potencio la microbiología de una forma extraordinaria justo en la epoca en las que enfermedades tales como difteria, paludismo, cólera atacaban el mundo.
-
Louis Pasteur en 1885 aplica su tratamiento al joven Joseph Meister, quien había estado expuesto al virus de la rabia, y lo salva. Sólo en los 15 meses siguientes más de 2.500 víctimas de mordeduras de perros rabiosos fueron tratadas de la misma manera.
-
El botánico Dimitri Yosifovich Ivanoski descubrió el primer virus conocido, virus del mosaico del tabaco. Al descubrir nuevas clases de virus y de bacterias y al asociarlos con enfermedades humanas fue posible conocerlos mejor y encontrar el modo de combatirlos.
-
El patologo Karl Landsteiner descubre la existencia de distintos grupos sanguíneos, lo que le permite explicar las causas de la incompatibilidad entre estos y prevenir sus fatales consecuencias.
-
Paul Erlich desarrolla los primeros métodos quimioterápicos el utilizó la quimioterapia experimental que se basaba en el concepto de afinidad selectiva. Esto último requería encontrar moléculas que actuaran sobre la causa de la enfermedad pero no dañar al organismo normal.
-
Twort propuso que la contaminación bacteriana podría ser la fuente de la "sustancia esencial" necesaria para la supervivencia del virus.
-
Nace cuando Bernstein describe en 1921 el modelo de transmisión hereditaria de los cuatro grupos sanguíneos principales, basándose en el análisis estadístico de sus proporciones relativas, y con el descubrimiento por Landsteiner y Levène de los nuevos sistemas MN y P.
-
El investigador Frederick Griffith demostro que las bacterias son capaces de transferir informacion genetica mediante un proceso llamado transformacion. Para ello utilizo cepas neumococos y los inyecto en ratones.
-
Cornelius Van Niel postulo el papel esencial que juegan los microorganismos en los ecosistemas, las fotosintesis anoxigenica la describe como un proceso fotosintetico que no genera oxigeno y que es exclusivo de microorganismos procariontes.
-
Frits Zernike fue un físico neerlandés ganador del premio Nobel de Física por su invención del microscopio de contraste de fases que permite ver microorganismos vivos.
-
Avery, MacLeod y McCarty publicaron sus resultados fueron muy pocos los que concluyeron que los genes estaban compuestos de ADN ya que esa época era difícil imaginar que una molécula compuesta sólo de cuatro bases nitrogenadas pudiera tener toda la información genética que de los seres vivos.
-
Delbrück y Alfred Day Hershey, trabajando independientemente uno del otro, descubrieron que el material genético de diferentes clases de virus podía recombinarse dando origen a nuevos tipos de virus.
-
Florey y Chang. Penicillium notatum crean la penicilina, fue el primer antibiótico que se desarrolló. La terramicina y la estreptomicina siguieron a la penicilina.
-
James Watson consagra todo su tiempo a la estructura de la molécula ADN, basándose en análisis cristalográficos por rayos X de Rosalind Franklin, sobre las competencias específicas en genética y en procesos biológicos de Crick y en cristalografía de Watson, proponen la estructura en doble hélice de la molécula de ADN.
-
El Dr. Stanley Cohen y el Dr. Herbert Boyer utilizan genes bacterianos para realizar el primer experimento satisfactorio con ADN recombinante, en el que se introdujo una molécula de ADN recombinante en una célula para su replicación.
-
Carl Woese demostró que las arqueobacterias presentan una línea evolutiva diferente a las bacterias debido a que la taxonomía filogenética se basaba en la secuenciación del ARN ribosómico 16S y se dividío a los procariotas en dos grupos evolutivos diferentes, en un sistema de tres dominios: Arquea, Bacteria y Eukarya.
-
Luc Montagnier descubrio el virus de VIH como causa del sida.
-
El médico inglés W. Roberts había descrito las propiedades antibióticas de ciertos cultivos de hongos contra las bacterias, e introdujo en Microbiología el concepto de antagonismo.
-
Clements y Bullivant descubren Epulopiscium fishelsoni, la mayor célula procariota esta gran bacteria, que sólo se ha encontrado en el intestino de surgeonfish, es de 10 a 20 veces más grande que cualquier otra bacteria.
-
Craig Venter ofrece un método de secuenciación más rápido y, junto a Hamilton O. Smith, trazan el genoma de la bacteria 'Haemophilus influenzae. La secuenciacion del genoma ha sido uno de los proyectos mas ambiciosos del hombre en el mundo de la ciencia.
-
Aparece en China la neumonía atípica (síndrome respiratorio agudo, SARS), enfermedad respiratoria producida por un coronavirus.
-
Una nueva vacuna impide la desaparición de uno de los animales más simbólicos de Australia. Las poblaciones silvestres están siendo acabadas en algunas regiones del país por la bacteria de la clamidia, por lo cual las primeras vacunas aplicadas los animales comenzaron a mostrar una respuesta inmune a los sesenta días de ser vacunados.
A list shows items. A timeline shows sequence.
Use Timetoast to make dates, milestones, and turning points easier to understand in a clear visual format. Timetoast is a timeline maker for work, school, research, and stories.